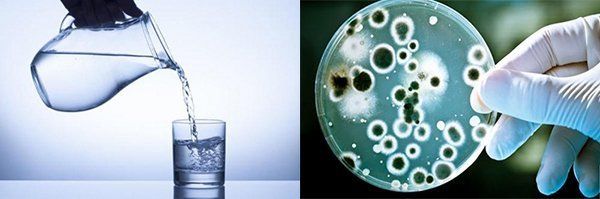

Uống quá nhiều hoặc quá ít nước không chỉ ảnh hưởng đến sức khỏe da mà còn làm suy giảm hoạt động của hệ bài tiết. Để duy trì làn da khỏe mạnh và hệ tiêu hóa hoạt động hiệu quả, hãy duy trì lượng nước cần thiết mỗi ngày.
Tiêu chuẩn uống 2 - 2,5 lít nước mỗi ngày là quan trọng. Việc uống quá ít có thể làm da lão hóa và gây stress cho cơ bàng quang và thận. Ngược lại, uống quá nhiều có thể dẫn đến tiểu nhiều và làm giảm sự tập trung.
 Uống không đúng lượng nước cần thiết là một sai lầm phổ biến
Uống không đúng lượng nước cần thiết là một sai lầm phổ biến Uống quá nhiều hoặc quá ít nước
Uống quá nhiều hoặc quá ít nướcĐun nước nhiều lần không phải là cách tốt để diệt khuẩn. Thực tế, thói quen này có thể gây hại bởi việc tăng nguy cơ hấp thụ kim loại nặng như chì, cadmium. Việc uống nước đun lại nhiều lần có thể ảnh hưởng đến sức khỏe, gây gián đoạn trong quá trình vận chuyển máu, tăng nguy cơ tim đập nhanh, và gây khó khăn trong hô hấp.
Đun nước nhiều lần tạo điều kiện cho kim loại nặng kết tủa, khiến chúng dễ dàng xâm nhập vào cơ thể. Thói quen này không chỉ ảnh hưởng đến tim mạch mà còn có thể đe dọa đến tính mạng.
 Uống nước đun lại nhiều lần có thể gây nguy hiểm đến sức khỏe
Uống nước đun lại nhiều lần có thể gây nguy hiểm đến sức khỏe Nước đun lại nhiều lần
Nước đun lại nhiều lầnNước đun sôi có thể tiệt trùng, nhưng uống nước ngay khi vừa mới đun sôi có thể tăng nguy cơ ung thư. Nhiệt độ cao tạo điều kiện cho sự hình thành các chất gây ung thư như halogen, chloroform trong nước. Việc này không chỉ có thể gây nguy hiểm cho sức khỏe mà còn có thể làm tổn thương miệng và họng. Hãy chờ nước mát đi trước khi uống để tránh rủi ro này.
Uống nước ngay khi vừa mới đun sôi không chỉ tăng nguy cơ ung thư mà còn có thể gây bỏng và hại cho miệng và họng. Hãy chờ cho nước nguội trước khi sử dụng để đảm bảo an toàn cho sức khỏe.
 Uống nước vừa mới đun sôi có thể tăng nguy cơ ung thư
Uống nước vừa mới đun sôi có thể tăng nguy cơ ung thư Uống nước khi vừa mới đun sôi
Uống nước khi vừa mới đun sôiKhông nên hoàn toàn từ chối nước trước khi đi ngủ. Trong giấc ngủ, cơ thể vẫn hoạt động và cần nước để duy trì chu trình hoạt động của các cơ quan. Uống một ít nước trước khi đi ngủ giúp duy trì tuần hoàn, hô hấp, tránh tiểu đêm và bảo vệ giấc ngủ. Đừng quên giữ lượng nước vừa đủ để đảm bảo sức khỏe toàn diện.
Không uống nước trước khi đi ngủ có thể gây mất ngủ và ảnh hưởng đến giấc ngủ trọn vẹn. Duy trì một lượng nước phù hợp trước khi đi ngủ giúp tránh tình trạng tiểu đêm và giữ cho cơ thể hoạt động ổn định, ngăn chặn cảm giác uể oải khi thức dậy.
 Không uống nước trước khi đi ngủ dễ bị mất ngủ
Không uống nước trước khi đi ngủ dễ bị mất ngủ Không uống nước trước khi đi ngủ
Không uống nước trước khi đi ngủDưỡng độ nhu cầu nước của cơ thể là bí quyết giữ gìn sức khỏe và làm đẹp. Hãy chú trọng uống nước định kỳ và khoa học, tránh uống quá nhiều hoặc quá ít nước. Lưu ý để không uống nhiều nước trước khi đi ngủ để tránh tình trạng tiêu đêm gây ra sự gián đoạn của giấc ngủ.
Uống nước không điều độ có thể gây ra các vấn đề về thận và ảnh hưởng đến sức khỏe nói chung. Hãy duy trì thói quen uống nước một cách khoa học, không đợi đến khi cơ thể quá khát mới uống, và tránh uống quá nhiều nước trước khi đi ngủ để ngủ một giấc đầy đủ và không bị gián đoạn.
 Uống nước không điều độ gây các vấn đề về thận
Uống nước không điều độ gây các vấn đề về thận Uống nước không điều độ
Uống nước không điều độBuổi sáng, sau khi thức dậy, cơ thể cần được bổ sung nước để giải độc và khôi phục năng lượng sau giấc ngủ. Việc uống một cốc nước ngay sau khi thức dậy giúp tăng cường sự tỉnh táo, kích thích tuần hoàn máu và cung cấp năng lượng cho cơ thể. Hãy hình dung cốc nước ấm áp như là một cách 'đánh thức' cơ thể, giúp bạn bắt đầu một ngày mới với tinh thần minh mẫn.
Uống nước sau khi ngủ dậy giúp đào thải chất thải từ cơ thể, cải thiện sự tuần hoàn máu và nạp năng lượng cần thiết cho cơ bắp và não bộ. Thói quen này giúp ngăn chặn tình trạng mệt mỏi và uể oải do thiếu nước, đồng thời là bước quan trọng để bắt đầu một ngày mới khỏe mạnh.
 Bạn sẽ bị mệt mỏi nếu không uống nước khi thức dậy
Bạn sẽ bị mệt mỏi nếu không uống nước khi thức dậy Không bao giờ bỏ qua việc uống nước sau khi thức dậy
Không bao giờ bỏ qua việc uống nước sau khi thức dậy
7. Sử dụng nước lọc thay vì nước ngọt có gas
Điều này là thói quen của rất nhiều người, đặc biệt là các bạn trẻ đơn giản vì những đồ uống đó ngon, lạ miệng và kích thích vị giác, khứu giác. Bạn chỉ nên uống một lượng nhỏ nước có gas để giải khát trong những ngày hè nóng bức. Việc sử dụng hoàn toàn nước lọc sẽ tạo điều kiện cho những hóa chất gây hại trong nước này như đường hóa học, chất bảo quản, hương liệu tổng hợp có thể gây hại cho sức khỏe của răng miệng, đường ruột, tim mạch và da liễu. Những chất này chỉ làm bạn tỉnh táo tạm thời rồi nhanh chóng đẩy bạn tới tình trạng mệt mỏi, uể oải hơn. Hãy nhớ rằng, nước lọc tinh khiết luôn là lựa chọn hàng đầu và là chân lý.
 Các hóa chất, chất bảo quản, và đường trong những loại đồ uống này có thể đưa sức khỏe của bạn xuống cấp nhanh chóng
Các hóa chất, chất bảo quản, và đường trong những loại đồ uống này có thể đưa sức khỏe của bạn xuống cấp nhanh chóng
8. Uống nước khi đang thưởng thức bữa ăn
Theo các chuyên gia dinh dưỡng, thói quen uống nước trong lúc ăn cần phải bị loại bỏ vì nó có thể gây ảnh hưởng không tốt đối với quá trình tiêu hóa, tạo điều kiện cho sự tích tụ mỡ trong cơ thể tăng cao. Dù là bất kỳ loại nước nào được uống trong thời gian ăn cũng sẽ làm tăng kích thước dạ dày, làm chậm quá trình tiêu hóa thức ăn. Điều này có thể dẫn đến dao động đột ngột của insulin, tạo điều kiện cho mỡ tích tụ nhiều hơn trong cơ thể. Đồng thời, nó còn làm trở ngại cho quá trình hấp thụ dinh dưỡng.
 Uống nước trong khi thưởng thức bữa ăn
Uống nước trong khi thưởng thức bữa ăn Hãy tận hưởng nước khi bạn đang thưởng thức bữa ăn
Hãy tận hưởng nước khi bạn đang thưởng thức bữa ăn
9. Hãy chọn nước uống đảm bảo vệ sinh
Với sự phát triển nhanh chóng của nền kinh tế, lượng rác thải đổ ra môi trường ngày càng tăng, góp phần vào tình trạng ô nhiễm môi trường đất, nước, và không khí. Nhiều khi chúng ta quá chủ quan về sức khỏe của mình và không quan tâm đến chất lượng của nước mình đang uống. Việc chỉ cần sôi là đủ còn ít quan tâm đến nguồn gốc của nước có thể gây hại. Điều này có thể gây nguy hiểm, khi các chất độc hại có thể xâm nhập vào cơ thể và gây tổn thương cho cơ quan nội tạng. Vì vậy, việc đảm bảo rằng nước đã được lọc kỹ và được khử trùng hoàn toàn trước khi uống là hết sức quan trọng.
 Nước bẩn là mối đe dọa lớn nhất đối với sức khỏe
Nước bẩn là mối đe dọa lớn nhất đối với sức khỏe Uống nước mà không đảm bảo vệ sinh là nguy hiểm
Uống nước mà không đảm bảo vệ sinh là nguy hiểm
10. Uống nước ngay sau khi hoạt động mạnh hoặc tập thể dục
Khi tập thể dục mạnh, cơ thể chúng ta đang đòi hỏi nước. Nhưng việc uống nước ngay sau khi vận động sẽ làm giảm nồng độ muối trong máu. Hơn nữa, nó còn kích thích mồ hôi đồng thời đẩy nhanh tốc độ tiêu thụ muối. Mồ hôi không chỉ mang theo muối mà còn làm giảm nồng độ muối trong máu. Điều này tương tự như việc chúng ta biến một địa hình cao thành địa hình thấp, nước sẽ nhanh chóng chảy xuống địa thấp, trong khi chất dinh dưỡng khó vận chuyển đến các tế bào. Điều này có thể dẫn đến tình trạng cơ thể thiếu chất dinh dưỡng, màu da tái xanh, nhịp tim nhanh, thở gấp, v.v…
 Uống nước ngay sau khi tập thể dục mạnh
Uống nước ngay sau khi tập thể dục mạnh Không quên uống nước sau khi vận động mạnh
Không quên uống nước sau khi vận động mạnh